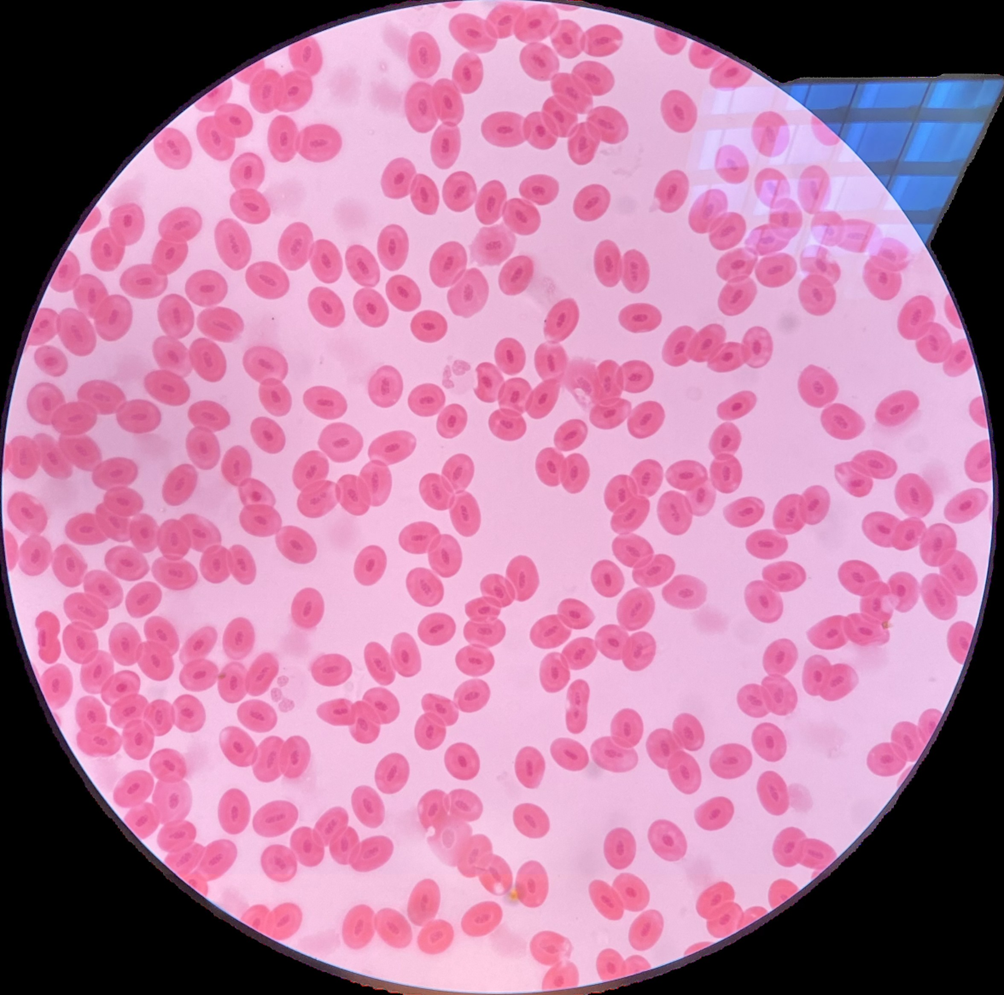

1/37
Looks like no tags are added yet.
Name | Mastery | Learn | Test | Matching | Spaced | Call with Kai |
|---|
No analytics yet
Send a link to your students to track their progress

Golgi complex in a nerve cell from the spinal ganglion (OsO4) Contians, golgi complex and nucleus

Mitochondria in epithelial cells of the proximal tubule in the kidney (Heidenhain’s iron hematoxylin) contains: mitochondrea, lumen and nucleus

Protein granules in the skin of axolotl (H & E), Contains pgment cell in connective tissue, connective tissue and epitelium

Glycogen in liver cells (MacManus), contains: glycogen granules and liver cell nulcei

Lipids in liver cells of axolotl (Carmine+OsO4) contains: lipid cell drolets and liver nuclei

Pigment inclusions (Unstained) contails, pigment granules and nucleus

Simple squamous epithelium [Mesothelium; mesentery] (silver
impregnation), contains, nucleus and cell membrane

Simple cuboidal epithelium from kidney tubules (van Gieson)

Simple columnar epithelium from small intestine (H&E) contaisn, goblet cells, absroptive cells and connective cells

Pseudostratified epithelium from trachea (Heidenhain’s iron
hematoxylin) contains, goblet cells, cilliated cells, connective tissue, basal cells

Stratified non-keratinized squamous epithelium from esophagus (H&E) contains, superficiale, pricle, basal and connective layer

Epidermis from fingertip (H&E), horney, pricle, clear, basal and connective tissue


Transitional epithelium from the ureter (Azan), superficiale, basal and intercalated layers

Glandula parotis (H&E), lumen, senseru sectretory cells

Glandula sublingualis (H&E), luemn mucous secretory cells,

Frog’s blood (H&E)


Human blood smear (Pappenheim), basophils, neutrophils, eosophils, lymphoctes and monocytes

Red bone marrow (Pappenheim)


Loose connective tissue (H&E and resorcin-fuchsin), connective tissue, elastic fibers


Dense irregular connective tissue (H & E and Heidenhain`s ironhem.), connective tissue, epidermis, dermis and fibroblasts

Dense regular connective tissue (H & E) connective tissue, fibroblasts and tendon cells


Mucous connective tissue (H&E), fibroblast, connective tissue and intercelated cells


Reticular connective tissue from the lymph node (H&E), connective tissue, lyphoctes and reticular cells

Adipose tissue surrounding the adrenals (H&E)nuclei, extraced droplet

Mast cells from the thymus (Brachet)

Hyaline cartilage from the trachea (H&E), hylaine and chondrocytes

Elastic cartilage from the epiglottis (Carmine-resorcin-fuchsin), elastic fibers, chondrocytes

Fibrocartilage from the disk of knee joint (H&E), collogen fiers, condrocytes

Transverse section of the dried bone (acidic fuchsin or thionin-
picrinic acid),

Longitudinal section of the decalcified bone (H&E), clanales and oestocytes

Bone formation (Carmine-picroindigocarmine), bone marrow and zones of cartilage

Smooth muscle (Van Gieson and PAS)

Skeletal muscle [longitudinal section] (Weigert`s hem.)

Myocardium [longitudinal & cross-section] (Heidenhain`s ironhem.)

Motor neuron from the spinal cord (Thionin), dendrites and nissl esubstance

Isolated nerve fibers from the frog`s sciatic nerve (Carmine+
OsO4)axon, ranviers node, schmid-lantermanns incisure, myelin shearth, neirolemma

Pacian corpuscles (H & E)

Cross-section through a large peripheral nerve (Azan), blood vessel, fasccle, adipose tissue perineurium and epinerurium